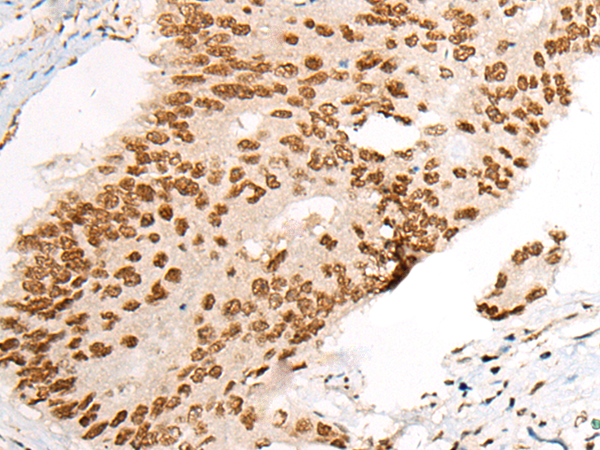

-
分类: 科研抗体货号: P12922别名: UPF3; HUPF3A; RENT3A应用: IHC反应种属: Human
-
分类: 科研抗体货号: P12931别名: JMS; SHS; XH2; XNP; ATR2; SFM1; MRX52; RAD54; MRXHF1; RAD54L; ZNF-HX应用: IHC反应种属: Human, Mouse
-
分类: 科研抗体货号: P12937别名: ASP1; BAE2; DRAP; AEPLC; ALP56; ASP21; CDA13; CEAP1应用: IHC反应种属: Human, Mouse, Rat
-
分类: 科研抗体货号: P12921别名: UNCX4.1应用: IHC反应种属: Human, Mouse
-
分类: 科研抗体货号: P12930别名: B37; HRS; NOD; DRPLA; D12S755E应用: IHC反应种属: Human, Mouse, Rat
-
分类: 科研抗体货号: P12936别名: TMEM3; B3GN-T3; B3GNT-3; HP10328; B3GAL-T8; beta3Gn-T3应用: WB,IHC反应种属: Human, Mouse
-
分类: 科研抗体货号: P12947别名: BICD; bic-D 1应用: IHC反应种属: Human, Mouse
-
分类: 科研抗体货号: P12929别名:应用: IHC反应种属: Human, Mouse
-
分类: 科研抗体货号: P12935别名: iGAT; iGNT; B3GNT1; B3GNT6; B3GN-T1; MDDGA13; BETA3GNTI应用: WB,IHC反应种属: Human, Mouse
-
分类: 科研抗体货号: P12946别名: MIST1; BHLHB8应用: WB,IHC反应种属: Human, Mouse, Rat

鄂公网安备42018502007531号
鄂公网安备42018502007531号

